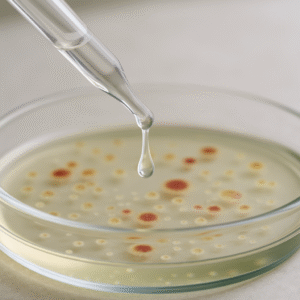

Showing all 6 results
-
1,2-Hexanediol
€0.00 – €33.00€27.27Price range: €0.00 through €33.00€27.27 (VAT incl.)(VAT excl.)Free sample100 g250 g500 g1 kg -
Caprylyl glycol
€0.00 – €150.00€123.97Price range: €0.00 through €150.00€123.97 (VAT incl.)(VAT excl.)Free sample50 g100 g250 g500 g1 kg5 kg -
Ethylhexylglycerin
€0.00 – €150.00€123.97Price range: €0.00 through €150.00€123.97 (VAT incl.)(VAT excl.)Free sample100 g250 g500 g1 kg5 kg -
Phenoxyethanol
€0.00 – €80.00€66.12Price range: €0.00 through €80.00€66.12 (VAT incl.)(VAT excl.)Free sample250 g500 g1 kg5 kg -
Potassium sorbate
€0.00 – €12.00€9.92Price range: €0.00 through €12.00€9.92 (VAT incl.)(VAT excl.) -
Sodium benzoate
€0.00 – €8.00€6.61Price range: €0.00 through €8.00€6.61 (VAT incl.)(VAT excl.)